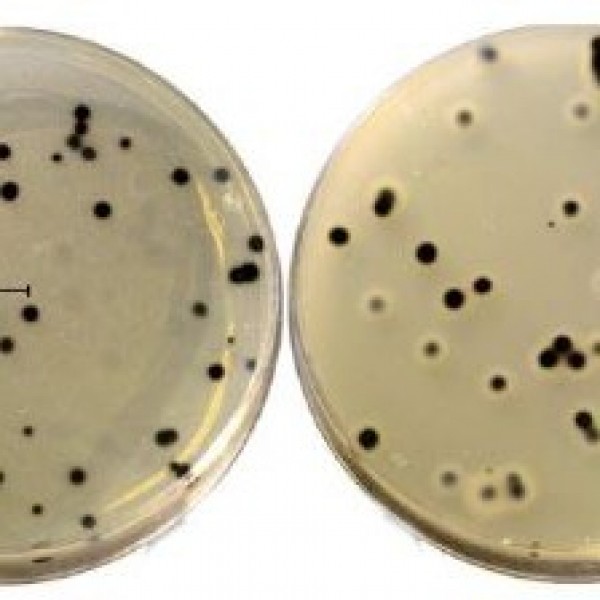

TSC Agar (Clostridium Perfringens)
TSC AGAR (CLOSTRIDIUIVI PERFRINGENS)
TSC Agar, CI. perfringens’in gıda örneklerinde tespiti ve sayımı için kullanılır.
CI. parfringens kolonileri besiyerinde iyi gelişen, siyah, yuvarlak koloniler olarak
gözlenir. Petriler 35-37 “C'de 24-48 saat, anaerobik ortamda inkübe edilir.
CI. parfringens anaerob bir mikroorganizma olduğundan, petrilerin
de anaerob ortamda inkübe edilmeleri gereklidir.